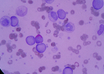

Monkey Fever: Treatment and precautions for clinicians by Dr. TV Rao
M3 India Newsdesk | Jan 07, 2019
Blood pressure meds tied to lung cancer risk: BMJ
M3 Global Newsdesk | Jan 07, 2019
Hey cardiologists, counselors are a must in your clinics and I.C.C.U : Dr Harish Shetty
M3 India Newsdesk | Jan 06, 2019
What every physician needs to know about the universal blood test for cancer
M3 Global Newsdesk | Jan 05, 2019
ASCO & IDSA guidelines: Outpatient management of fever and neutropenia in adults treated for malignancy
M3 India Newsdesk | Jan 03, 2019
HIV diversity and Circulating Recombinant Forms- Dr. Alaka Deshpande
M3 India Newsdesk | Jan 03, 2019
What is in store for Cardiology in 2019 – Can androids dream of eRabbit?
M3 India Newsdesk | Jan 02, 2019
New way to target lung lesions avoids open chest surgery
M3 Global Newsdesk | Jan 02, 2019
Where should physicians invest their money in 2019?
M3 Global Newsdesk | Jan 01, 2019
Looking Back at 2018: Notable developments in Indian healthcare and policy
M3 India Newsdesk | Dec 31, 2018
Most read this week